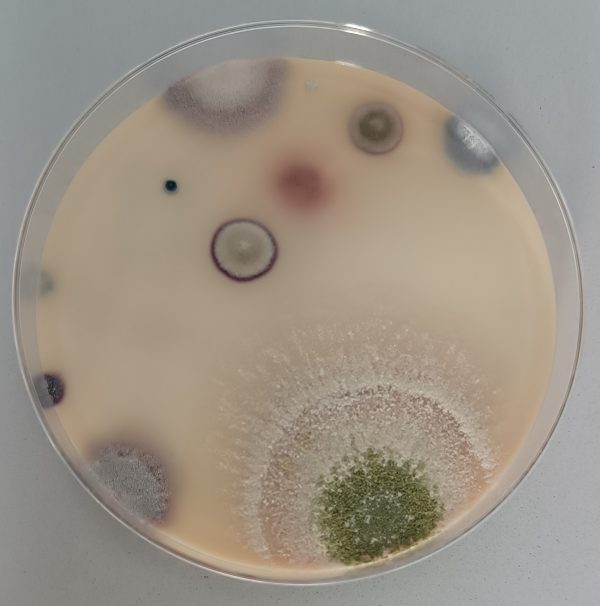

PAFSE Quarterly Newsletters
Since October 2022, PAFSE newsletters have been sent quarterly to all subscribed members. They contain news and updates about the project, and also useful links for the subscribers, namely the project’s social media. You may find below all the newsletters sent so far.
If you wish to stay in touch with PAFSE news, you may subscribe to PAFSE newsletter.
PLATFORMS
![]() |
![]() |
| Are you aware about Partnerships for Science Education (PAFSE) project? Have you ever heard about it or met our team? PAFSE is a Science Education Project that addresses the challenges of Public Health. It was approved under Horizon 2020 programme and integrates 9 partners from 4 European countries: Portugal, Cyprus, Greece, Poland.
PAFSE consortium took a couple of meetings to discuss the components and contents of Photodentro PAFSE, a European Repository of STEM (Science, Technology, Engineering, Mathematics) educational resources addressing public health. The repository is launched and will be continuously updated! If you are a teacher, researcher, instructional designer, professor, educator, technology developer, scientist, engineer, public health specialist, STEM specialist, or any other professional interested in innovative learning resources for science education, click here to browse Photodentro PAFSE. Additionally, PAFSE provides you a collaborative, social and extendable Digital Educational Space, e-me platform, a working and collaboration space for pupils and teachers, that also provides resources to support teaching and learning. e-me was initiated in Greece and under its European edition is now open and free to anyone interested in Europe, schools, teachers, pupils, parents, academics, institutions, etc. It supports four languages (English, Greek, Portuguese and Polish). If you wish to know more and/or register to e-me click here. |
| About the Project | Stakeholders | Contacts |
No longer want to receive these emails? Unsubscribe.
|
|
|
|
|
|
|
|
|
|
|
|
|
This project has received funding from the European Union’s Horizon 2020 research and innovation program under grant agreement No 101006468.
| About the Project | Stakeholders | Contacts |
| No longer want to receive these emails? Unsubscribe. |
|
|
|
|
|
|
|
|
|
|
|
|
|
|
|
WHERE ARE WE?
Welcome to the latest edition of the PAFSE project newsletter. Here, we share updates and insights on our work to promote science education in schools and communities. We are excited to announce that we are entering the scale-up phase of our project, expanding our reach and impact to more regions and partners. We would also like to announce that we will soon make public new dates for our upcoming teacher professional developmentworkshops. These workshops offer educators the opportunity to learn about public health issues and learning in science from our experts and network. This newsletter is part of our ongoing effort to keep you informed and engaged with our project. We hope you find it useful. Thank you for your support and interest in the PAFSE project!
WHAT HAVE WE BEEN UP TO SO FAR?
HERE ARE SOME NEWS FOR YOU!
Celebrating International Science Day
In a remarkable event held on November 24th, at the National School of Public Health, the Partnerships for Science Education (PAFSE) Project came together with various stakeholders and partner schools to commemorate International Science Day.
National dissemination action of the PAFSE Project to School Groups and Live Science Clubs
On November 9, 2023, a nationwide publicity campaign for the PAFSE Project was carried out in Portugal, intended to School Groups and Live Science Clubs. This action, which was co-organized by the General Directorate of Education, was attended by 105 participants.
PAFSE organizes the “Digital Learning Objects for inquiry-based learning in public health”!
PAFSE members D. Chalkidis, G. Iatraki, P. Gaintatzis, and T. A. Mikropoulos organized the “Digital Learning Objects for inquiry-based learning in public health” workshop at the 13thNational Conference “Science Education and New Technologies in Education”
AMU: START of the next PAFSE workshops
Primary school from Krzyż Wlkp. students learned about the different faces of bacteria: Internal and external structure, division of bacteria into beneficial and pathogenic, places of existence and living conditions. Τhey collected all this information during workshops organized at the Faculty of Biology of Adam Mickiewicz University
This project has received funding from the European Union’s Horizon 2020 research and innovation program under grant agreement No 101006468.
| About the Project | Stakeholders | Contacts |
| No longer want to receive these emails? Unsubscribe. |
PAFSE Final conference: Open Schooling Innovations for Public Health Education
Save the date: 12 of July
Welcome to the latest edition of our newsletter, where we celebrate the power of collaboration in and for science education. We are thrilled to announce that the PAFSE project will organize an international conference on the 12th of July. This event will be held in Lisbon, at the Rectory of the NOVA University of Lisbon. The conference will not only reflect on the achievements and breakthroughs facilitated by PAFSE, but also look ahead to future projects, collaborations and initiatives. We look forward to seeing you there and celebrating our collective accomplishments. Stay tuned on the social networks and website, we will announce the conference program soon. You will be able to sign up and guarantee your spot soon!
WHAT HAVE WE BEEN UP TO SO FAR?
HERE ARE SOME NEWS FOR YOU!
PAFSE Azores Cluster, recently formed, develops science education activities!
Expolab – Ciência Viva Science Centre – is collaborating in the implementation of the educational scenario under the topic “Sustainable Development Goals” and organized a science education activity with students at Domingos Rebelo Secondary School.
Read More +
PAFSE Project in the media: Innovative Approach in Portuguese Schools
At the Góis School, an innovative approach is shaping the way road accidents are perceived. Far from being isolated incidents, they are seen as public health problems.
PAFSE Project Successfully Concludes Comprehensive Webinar Series
The PAFSE project has successfully completed a comprehensive series of insightful webinars. These sessions were designed to support teachers in creating effective technology-enhanced learning environments focused on public health.
AMU: Honorary patronage of the Mayor of Poznań
We are pleased to announce that President Jacek Jaśkowiak has granted the “PAFSE – Partnerships for Science Education” project the Honorary Patronage of the Mayor of Poznań, as an expression of personal support and appreciation for the project. Thank you.
This project has received funding from the European Union’s Horizon 2020 research and innovation program under grant agreement No 101006468.
| About the Project | Stakeholders | Contacts |
| No longer want to receive these emails? Unsubscribe. |
PAFSE Final conference: Open Schooling Innovations for Public Health Education
Welcome to the latest edition of the PAFSE newsletter. PAFSE final conference was held on the 12th of July, in Lisbon, Portugal. The event brought together educators, researchers, and policymakers to discuss innovations in open schooling approaches for public health education. The conference, held at the Rectory of the NOVA University Lisbon, was an engaging exchange of ideas and event of case studies from across Europe, with a focus on evaluating the impact of PAFSE and exploring its future directions. To add onto this surge of positive notes, we are thrilled to announce that the European Research Agency has recognised PAFSE as one of the most innovative and impactful projects in the EU, contributing significantly to the European Research Area- you may read more about this in one of the articles below. We truly hope that you appreciate this newsletter, as it briefly summarises our progress, acknowledges our achievements, and outlines the collaborative efforts that lie ahead.
WHAT HAVE WE BEEN UP TO SO FAR?
HERE ARE SOME NEWS FOR YOU!
PAFSE Final Conference Marks a Milestone in the Project and in Public Health Education

Read More +
University of Cyprus: Artifacts from the European Research Project Partnerships for Science Education (PAFSE)
Students from PAFSE schools in Cyprus documented their research findings and the processes of their school projects by creating posters, PowerPoint presentations, debates, theatrical performances, brochures, and articles for local social media and newspapers.
Read More +
PAFSE integrates a list of innovative and impactful EU projects that have made significant contributions to European Research Area
PAFSE was considered by the European Research Agency (ERA) as one of the most innovative and impactful projects in the European Union due to its significant contribution to the European Research Area (EEA).
In preparation for a high-level stakeholder ERA conference to be held on 18-19 September 2024, the agency selected a number of innovative and impactful EU projects that have made significant contributions to the ERA under Actions within the current ERA Policy Agenda.
This project has received funding from the European Union’s Horizon 2020 research and innovation program under grant agreement No 101006468.
| About the Project | Stakeholders | Contacts |
| No longer want to receive these emails? Unsubscribe. |



PAFSE was presented at the Portuguese Interinstitutional Days of Pedagogical Innovation, an initiative open to higher education teachers interested in their professional pedagogical development.
The learning activities were organized under the scope of the partnership between Escola Nacional de Saúde Pública, Universidade Nova de Lisboa and Sporting Clube de Portugal for #PAFSE project.
The scientific responsible of the Project for the University of Ioannina Professor Anastasios Mikropoulos accompanied by members of the Research Team of the University of Ioannina, met with officers of the Directorate of Secondary Education of Arta, Principals and Biology and Chemistry teachers of the 2nd, 3rd and 5th High Schools of Arta.
On the 8th of february a team from Escola Nacional de Saúde Pública, Universidade Nova de Lisboa visits Escola Secundaria Professor Ruy Luis Gomes, with a couple of partners, to: share real and inspiring stories; demystify myths about science and STEM professions; explore problems connected with sustainable development; find creative solutions; systematize information about STEM.
In the context of the 2030 Agenda for Sustainable Development, Portugal will present a National Voluntary Report in July 23, a reflective exercise of collecting and reporting information on the progress made in the 17 Sustainable Development Goals. In this exercise, the Presidency of the Council of Ministers, together with the Commission for Coordination and Regional Development of Lisbon Region, held a Participatory Assembly on March 29th.